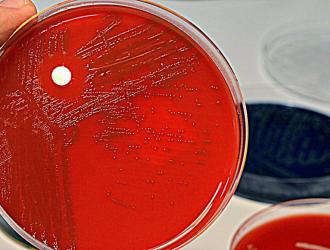

Se fosse una malattia sarebbe la seconda più letale al mondo, con 7-9 milioni di morti l'anno, molti di più rispetto ad esempio ai 7-800.000 dell'HIV-AIDS.
Quella legata alla sepsi, hanno ricordato lo scorso 13 settembre gli esperti in occasione del World Sepsis Day, giornata mondiale...